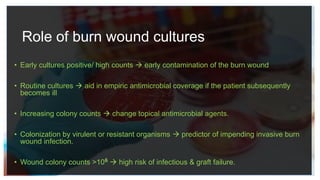
Role of burn wound cultures
• Early cultures positive/ high counts  early contamination of the burn wound
• Routine cultures  aid in empiric antimicrobial coverage if the patient subsequently
becomes ill
• Increasing colony counts  change topical antimicrobial agents.
• Colonization by virulent or resistant organisms  predictor of impending invasive burn
wound infection.
• Wound colony counts >106  high risk of infectious & graft failure.

This document provides an overview of burns, including:
1) Burns are injuries caused by direct contact with heat, chemicals, electricity, radiation or flame. Thermal burns are the most common type.
2) Burn classifications include depth of burn (1st-4th degree), type of burn (thermal, chemical, electrical etc.), and percentage of total body surface area burned.
3) Burn pathophysiology involves local effects like edema formation and systemic effects like hypovolemia, increased vascular permeability, immune dysfunction and hypermetabolism.

































![Pathophysiology : Local Effects
• Edema in non-burned tissue
•Loss of capillary endothelial integrity
•Reduced transmembrane potentials of skeletal
muscle at the site of injury as well as away
from the site of damage [-90mv -70 to -80mv]
•Increase in intracellular Na & water leading to
edema](https://image.slidesharecdn.com/burns-210426145939/85/Burns-34-320.jpg)











![Pathophysiology
: Systemic
Effects
• Hypermetabolic response
• Phase I [ebb]
• First 48 hrs
• Decrease in
• cardiac output
• urine output
• O2 consumption
• BMR
• Impaired glucose tolerance with
hyperglycemia
47](https://image.slidesharecdn.com/burns-210426145939/85/Burns-46-320.jpg)
![Pathophysiology :
Systemic Effects
• Hypermetabolic response
• Metabolic variables gradually
increase within first five days post
injury to reach a plateau
• Phase II [flow]
• Increase in metabolic rate
• Urine cortisol
• Serum catecholamines
• Basal energy expenditure
• Serum cytokines
• Hyperdynamic state – increase in
cardiac output
• Insulin resistance
• Persists for upto 3 years
48](https://image.slidesharecdn.com/burns-210426145939/85/Burns-47-320.jpg)